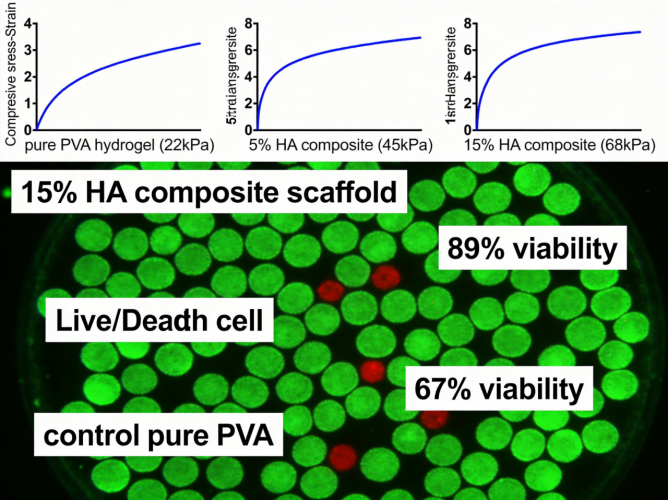
PVA水凝胶复合羟基磷灰石纳米粒软骨修复支架定制

水凝胶-纳米粒复合材料定制服务——西安齐岳生物
西安齐岳生物可针对明胶、海藻酸钠等多类水凝胶,提供与功能化纳米粒复合的定制服务,覆盖材料性能调控、结构设计及应用适配全流程。我们可根据科研与产业需求,可调控复合材料的机械强度、降解速率、药物负载能力等核心参数。同时配套完备的性能检测与技术支持,为客户提供从方案设计到样品交付的一体化解决方案。
一、核心定制类型
| 材料类型 | 特点 | 应用场景 | 定制周期 |
| 明胶水凝胶复合纳米粒 | 生物相容性优异,可降解,具备天然细胞黏附位点,纳米粒负载后缓释性能可控 | 组织工程支架、药物控释载体、创面修复敷料 | 10-15天 |
| 海藻酸钠水凝胶复合纳米粒 | 可快速离子交联成型,生物安全性高,纳米粒可增强机械性能与负载能力 | 细胞3D培养载体、止血材料、骨组织修复支架 | 8-12天 |
| 琼脂糖水凝胶复合纳米粒 | 热可逆凝胶特性,透明度高,纳米粒分散性好,力学性能稳定 | 食品保鲜涂层、生物分子固定载体、体外药物筛选模型 | 7-10天 |
| 聚乙烯醇(PVA)水凝胶复合纳米粒 | 机械强度优异,化学稳定性高,可通过物理/化学交联调控降解,纳米粒可优化界面相容性 | 软骨组织修复、人工关节软骨替代材料、耐磨损医用敷料 | 12-18天 |
| 壳聚糖水凝胶复合纳米粒 | 具备天然抗菌活性,可促进细胞增殖,纳米粒可提升药物负载与靶向递送能力 | 抗菌创面敷料、肿瘤靶向药物载体、皮肤组织工程支架 | 10-15天 |
| 胶原蛋白水凝胶复合纳米粒 | 细胞亲和性极强,结构与天然ECM类似,纳米粒可增强力学性能与缓释效率 | 真皮组织修复、干细胞培养载体、美容填充材料 | 12-20天 |
| 其他类型水凝胶复合材料 | 可根据需求定制聚乙二醇(PEG)、透明质酸等功能化水凝胶与纳米粒的复合物 | 个性化科研需求、特殊产业应用场景(如柔性电子基底、环境吸附材料) | 15-25天 |
二、定制维度和定制范围
| 定制维度 | 可选范围/类型 | 技术说明 |
| 纳米粒类型 | 无机纳米粒(羟基磷灰石、氧化铁、金纳米粒)、有机纳米粒(PLGA、聚乳酸、脂质体)、功能化纳米粒(靶向修饰、荧光标记) | 采用共混包埋、原位合成、表面接枝等技术实现纳米粒与水凝胶的稳定复合 |
| 纳米粒粒径范围 | 10-50nm、50-200nm、200-500nm、500nm-1μm | 通过乳化-溶剂挥发、微流控、水热合成等技术精准调控纳米粒粒径 |
| 水凝胶交联方式 | 物理交联(温度响应、离子交联、氢键作用)、化学交联(自由基聚合、席夫碱反应、点击化学)、双重交联 | 依据水凝胶类型与应用需求选择交联方式,平衡力学性能、生物相容性与降解性 |
| 功能化修饰 | 细胞黏附肽(RGD)修饰、靶向配体(叶酸、抗体)修饰、荧光基团(FITC、Cy5)标记、抗菌基团修饰 | 通过共价接枝、物理吸附等方式在水凝胶或纳米粒表面引入功能基团 |
| 尺寸和形状定制 | 微球(100μm-1mm)、块状(定制长宽高)、薄膜(10-100μm厚度)、3D打印复杂结构 | 采用乳化法、模具浇筑、3D生物打印等技术实现多样化尺寸与形状制备 |
| 孔径和孔隙率调节 | 孔径:10-50μm、50-200μm、200-500μm;孔隙率:50%-95% | 通过致孔剂(盐析、冷冻干燥)、纳米粒模板、3D打印参数调控实现孔径与孔隙率精准控制 |
| 机械强度调节 | 压缩模量:1-10kPa、10-100kPa、100kPa-1MPa、1MPa以上 | 通过交联度调控、纳米粒掺杂比例、水凝胶浓度调整实现机械强度优化 |
| 降解性能调控 | 降解周期:1-2周、2-8周、8-24周、24周以上 | 通过水凝胶交联密度、纳米粒降解性、复合材料组分比例调整实现降解速率控制 |
三、西安齐岳生物水凝胶-纳米粒复合材料定制案例
案例一:壳聚糖水凝胶复合载药纳米粒抗菌创敷料定制
定制需求:某创面修复科研团队需定制具备长效抗菌性能与药物缓释功能的创面敷料,要求材料为壳聚糖水凝胶复合载抗生素纳米粒,需满足:1. 对金黄色葡萄球菌的抑菌率≥95%;2. 抗生素缓释周期≥7天;3. 水凝胶孔隙率≥80%,适配创面组织细胞浸润。
设计方案:采用“纳米粒预负载-原位交联复合”工艺:先通过乳化溶剂挥发法制备载药PLGA纳米粒,再将纳米粒分散于壳聚糖溶液中,利用钙离子与壳聚糖的离子交联作用制备复合水凝胶。交付样品性能参数:对金黄色葡萄球菌抑菌率达98.2%,抗生素7天累计释放率为68.5%,孔隙率为85.3%,同时提供材料的SEM表征、抑菌圈测试、药物释放曲线等全套检测数据。

案例二:PVA水凝胶复合羟基磷灰石纳米粒软骨修复支架定制
定制需求:某骨科研究机构需定制适配软骨组织修复的支架材料,要求为PVA水凝胶复合羟基磷灰石(HA)纳米粒,核心需求:1. 压缩模量达50-80kPa,匹配天然软骨力学性能;2. 降解周期≥12周,适配软骨再生周期;3. 具备良好的细胞黏附性,支持软骨细胞增殖。
设计方案:采用“反复冻融-纳米粒原位矿化”双重交联工艺制备复合水凝胶:先通过反复冻融法制备物理交联的PVA水凝胶,再在水凝胶内部原位矿化生成HA纳米粒,提升材料力学性能与生物活性。交付样品性能参数:压缩模量为68kPa,12周降解率为32%,软骨细胞黏附率达89%,同时提供力学性能测试报告、降解曲线、细胞活死染色检测数据。
四、服务优势

1. 覆盖全品类水凝胶-纳米粒复合材料定制,满足多元化科研与产业需求
2. 具备多维度性能精准调控技术,可实现力学、降解、功能化的个性化定制
3. 拥有完备的材料性能检测平台,交付样品配套全套权威检测数据
4. 提供从方案设计、样品制备到技术支持的全流程一体化服务
5. 科研级定制经验丰富,可快速响应高难度、个性化的定制需求
五、相关文献支持
文献一:中文名称:水凝胶-纳米粒复合材料在组织工程中的应用进展
英文名称:Advances in Hydrogel-Nanoparticle Composites for Tissue Engineering
主要内容:系统综述了水凝胶-纳米粒复合材料的制备方法、性能调控策略,重点阐述了其在骨、软骨、皮肤等组织工程领域的应用,分析了该类材料的优势与未来发展方向,为组织工程材料的设计提供了全面的参考。
文献二:中文名称:功能化纳米粒复合水凝胶的药物控释系统研究
英文名称:Functionalized Nanoparticle-Hydrogel Composites for Drug Delivery Systems
主要内容:聚焦水凝胶-纳米粒复合体系的药物控释机制,详细介绍了不同功能化纳米粒对药物负载、靶向递送、缓释性能的调控作用,结合多项体内外实验数据,证明该类体系在肿瘤、慢性创面等疾病治疗中的应用潜力。
六、采购流程:
1) 需求沟通:客户通过线上咨询、电话沟通或邮件提交定制需求,明确材料类型、性能指标、应用场景等核心信息,我方技术团队进行初步评估。
2) 方案设计与报价:技术团队根据需求制定专属定制方案,明确制备工艺、性能检测项目、交付周期与费用,形成正式报价单与技术协议提交客户确认。
3) 合同签订与付款:客户确认方案与报价后,签订定制服务合同并支付预付款,我方启动定制制备流程。
4) 样品制备与检测:按照定制方案完成样品制备,同步开展性能检测,形成检测报告,期间可根据客户需求进行阶段性进度反馈。
5) 样品交付与技术支持:样品制备与检测完成后,交付样品及全套检测报告、技术资料,同时提供后续的技术咨询与性能优化建议。
6) 售后跟进:售后团队定期跟进客户使用情况,针对客户反馈的问题提供技术解决方案,保障客户科研与应用需求的实现。




 齐岳微信公众号
齐岳微信公众号 官方微信
官方微信 库存查询
库存查询